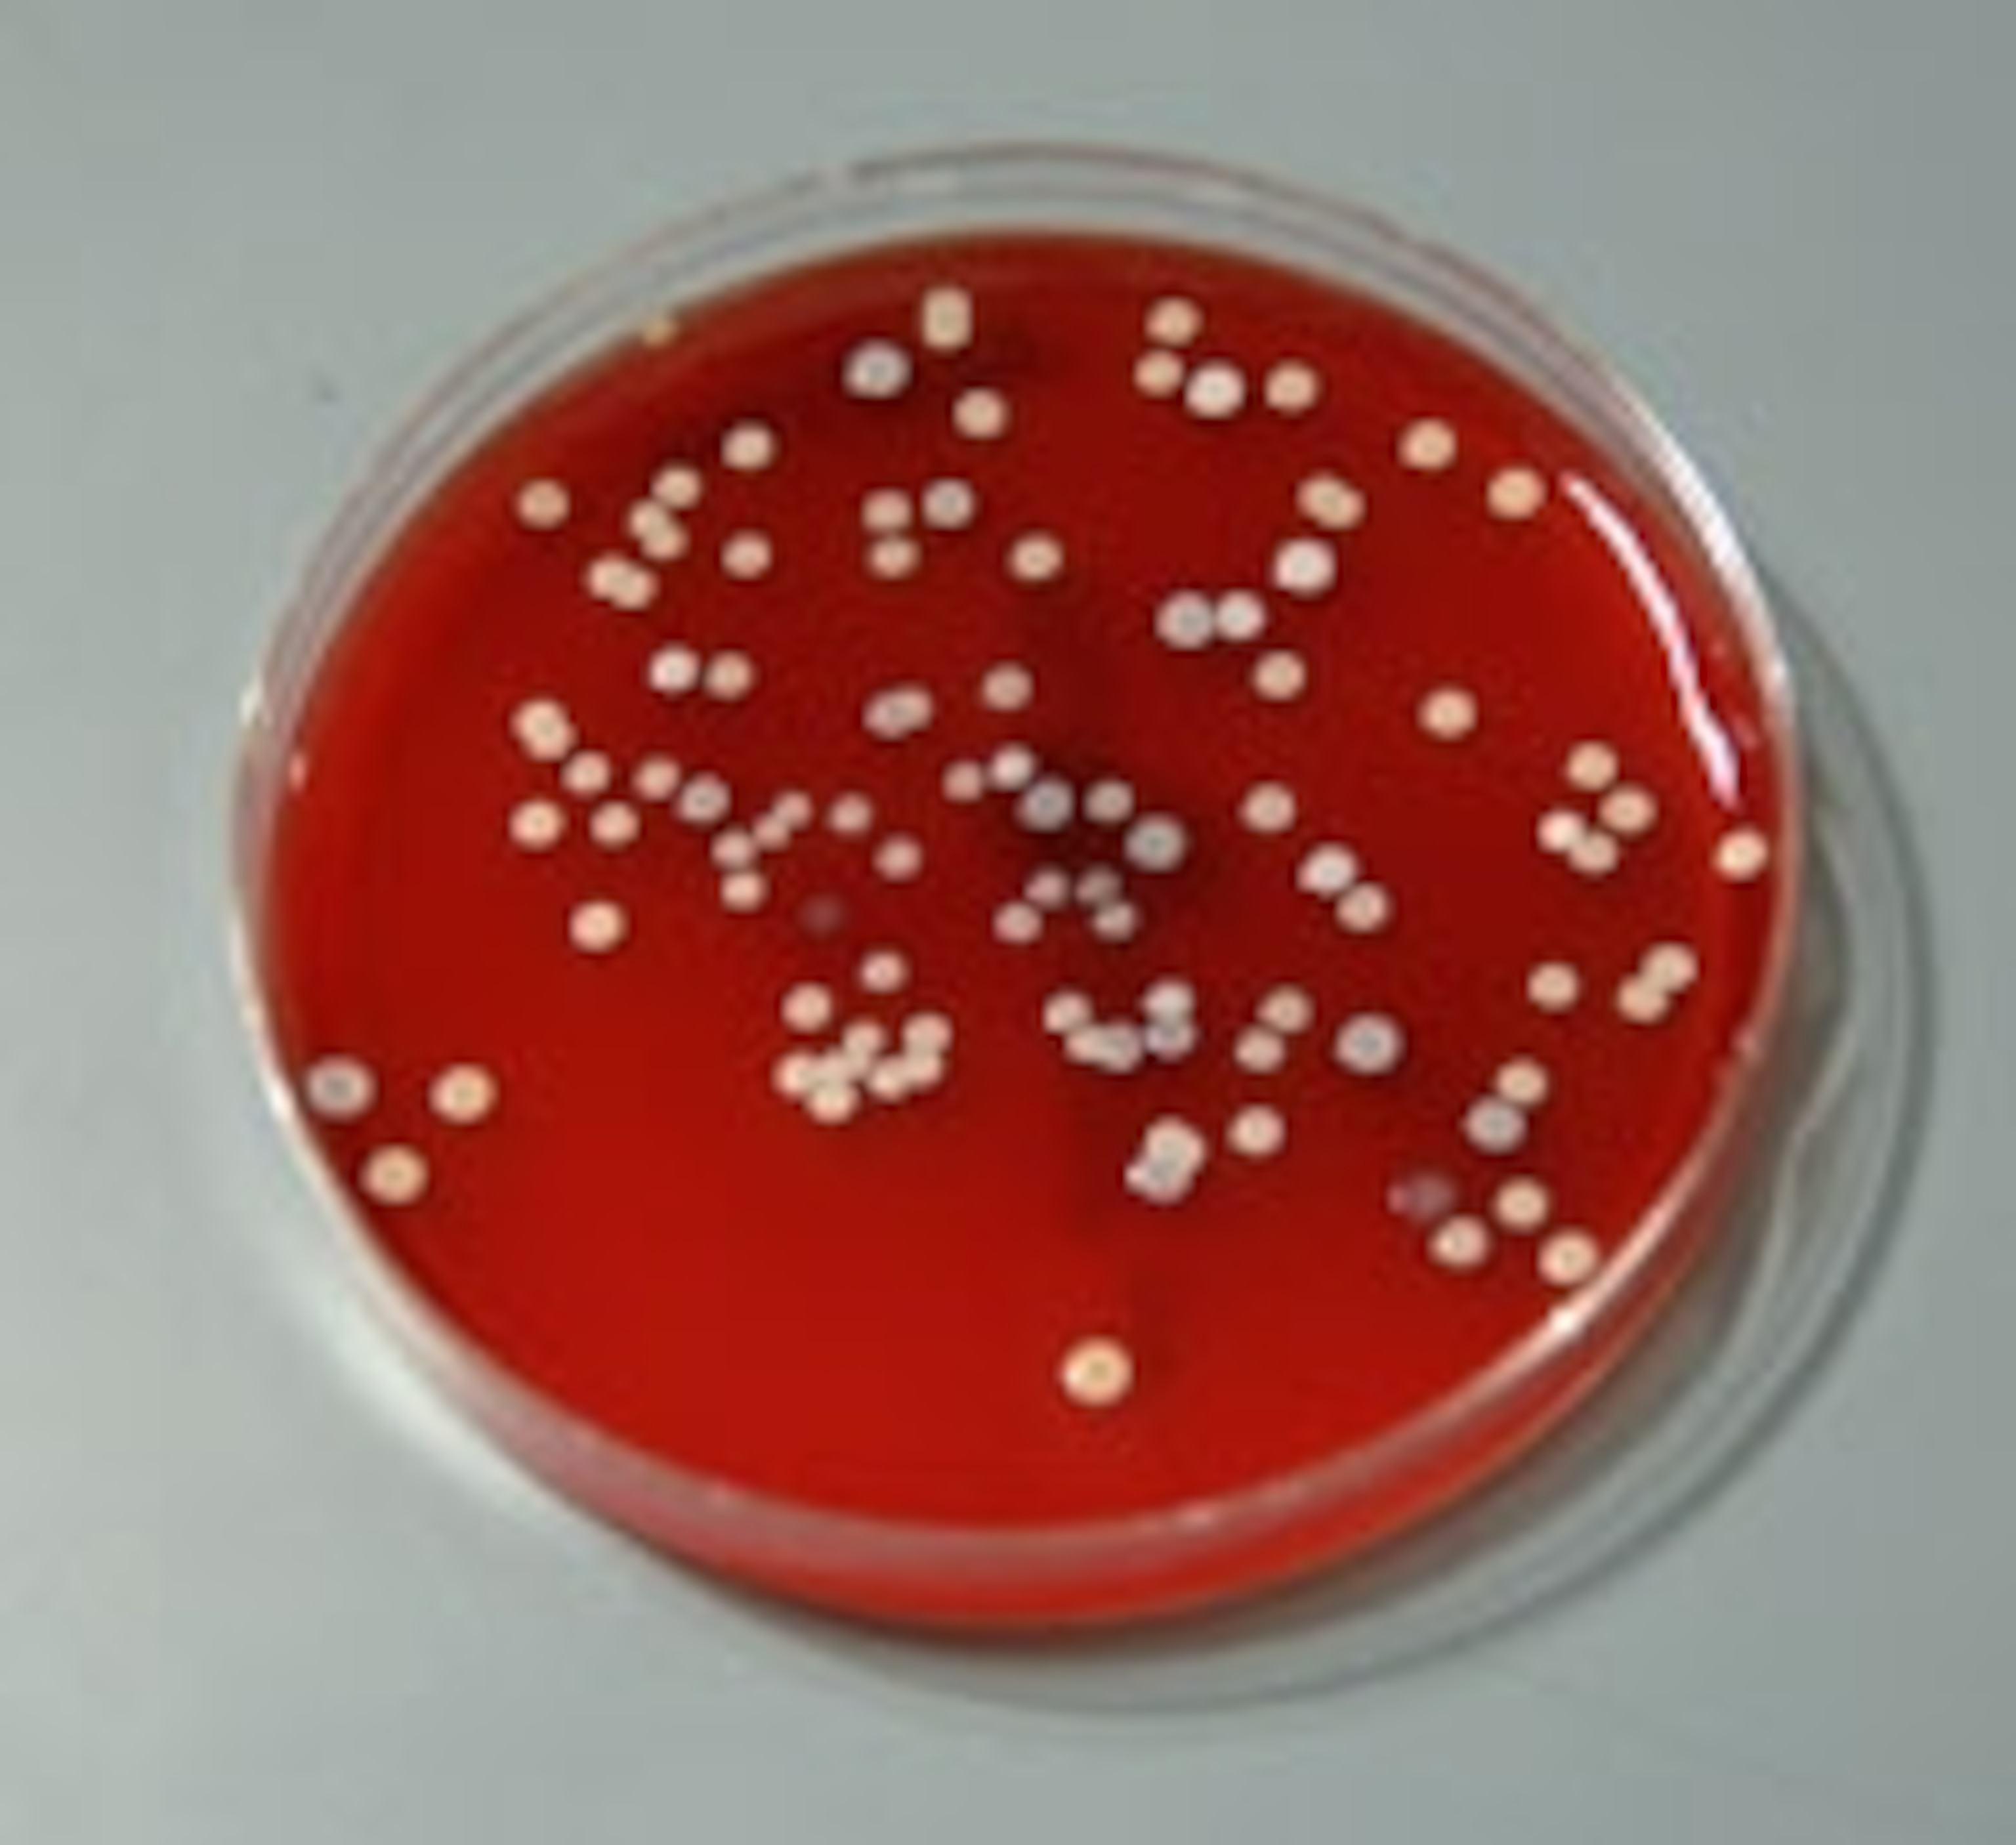

The bacterial zoo living on your skin
It’s a diverse melting-pot of different groups, with hundreds of different cultures living together in harmony, many sticking to their own preferred areas. No, not London, New York or any other cosmopolitan city; I’m talking about your skin. It may all look the same to you, but to the bacteria living on it, it’s an entire realm of diverse habitats.
From a microscopic perspective, the hairy, moist surface of your armpits is worlds apart from the smooth, dry skin of your forearms. Even though they are separated by mere inches, these patches of skin are as different to their microscopic residents as rainforests and deserts are to us.
The true diversity of the bacteria on our bodies has just been revealed by Elizabeth Grice from the National Human Genome Research Institute, who has done a thorough survey of our “skin microbiome”. She recruited 10 healthy volunteers and took swabs from 20 distinct patches of their skin, all areas that are often afflicted by skin disorders. These areas represent a broad range of habitats from the oily lakes of the eyebrows, nose, inner ear and upper chest, to the moist jungles of the groin, nose, armpit and navel, to dry deserts of the forearms and palm.
By sequencing the distinctive 16S rRNA gene of over 112,000 bacterial samples, Grice catalogued a much broader menagerie of microbes than expected, with representatives from 19 different phyla and 205 different genera. Previous attempts at doing this have been biased towards species that grow easily in laboratory conditions such as Staphylococcus, but Grice’s more thorough approach revealed a surprising degree of diversity. It also showed that bacteria from a specific body part have more in common than those from a specific person. Your butt microbes have more in common with mine than they do with your elbow microbes.

The nostril (both inside and the crease on the side) has the most uniform collection of microbes from person to person. Bacteria living here, along with those in the ear and the inguinal crease (where leg meets groin) are the most unchanging. When Grice collected new samples after 4-6 months, she found that these body parts provided the greatest residential security for bacteria.
Different groups of bacteria dominated the three major classes of habitats but in general, the dry and moist sites were richer in microbes than the oily ones. If you wanted to find the richest community of bacteria, you’d have to look no further than your own forearm with an average of 44 species*, while microbe-hunting in the crease behind the ear would yield the fewest finds, with just 15 species.
Grice hopes that her census will eventually tell us more about the dividing line between healthy and diseased skin, especially since certain skin disorders are more common at specific parts of the body. Eczema, for example, favours the inner bend of the elbow while psoriasis tends to show up on its outer face. Treatments for skin disorders will depend on preventing harmful bacteria from growing and encouraging helpful or harmless bacteria to take their place.
* ‘Species’ is a convenient short-hand here. Grice clustered her sequences into “operational taxonomic units”, groups that were 99% similar and reflected diversity at the species level.
Reference: Science 10.1126/science.1171700